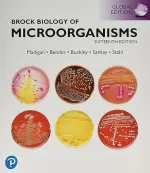
Brock Biology Of Microorganisms by Michael Madigan, John Martinko, Kelly Bender, Daniel Buckley, David Stahl, Thomas Brock, Paul Dunlap, David Clark, Matthew Sattley - Image 1

BiologyBrock Biology Of Microorganisms by Michael Madigan...
Brock Biology Of Microorganisms by Micha...
978-1-29-2404, 79-0,978-0-32, -164963-8,978, -1-29-201831-, 7,978-0-32-18, 9739-8,978-0-, 13-232460-1,9, 78-0-13-42619
Brock Biology Of Microorganisms by Michael Madigan, John Martinko, Kelly Bender, Daniel Buckley, David Stahl, Thomas Brock, Paul Dunlap, David Clark, Matthew Sattley
Enhance your understanding of microbiology with Brock Biology Of Microorganisms by Madigan et al. Dive into the world of microorganisms with comprehensive Class Notes, Exam Guides, and End of Chapter Solutions available. These resources will aid in your studies and exam preparation, providing a deeper insight into the fascinating realm of biology at the microbial level.
Daniel Buckley, David Clark, David Stahl, John Martinko, Kelly Bender, Matthew Sattley, Michael Madigan, Paul Dunlap, Thomas Brock
2
Documents
4.1
Rating
1
Types

